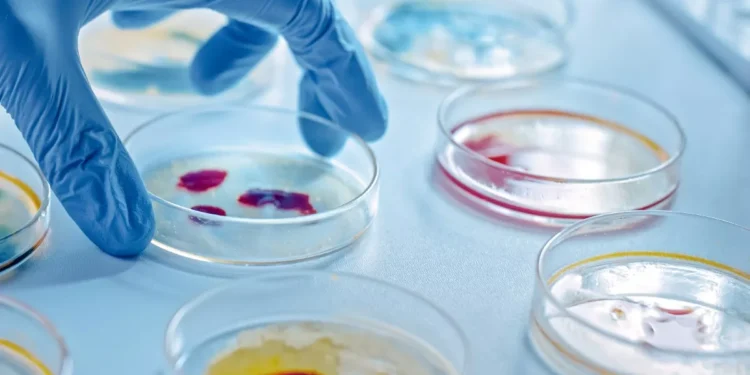
Θλιβερή πρωτιά της Ελλάδας στην ΕΕ σε θανάτους από λοιμώξεις – Το νέο σχέδιο του υπουργείου Υγείας για τα αντιβιοτικά

Τα αντιβιοτικά αποτελούν μια από τις μεγαλύτερες ανακαλύψεις του 20ου αιώνα, ωστόσο, η αλόγιστη, και πολλές φορές λανθασμένη χρήση τους, οδηγεί στην ανάπτυξη ανθεκτικών στα αντιβιοτικά μικροβίων. Το υπουργείο Υγείας δρομολογεί δύο μείζονες δράσεις για τον έλεγχο των λοιμώξεων
Σε δύο πυλώνες (ξανα)δομείται η εθνική προσπάθεια για την αντιμετώπιση της αύξησης των λοιμώξεων, λόγω της μικροβιακής αντοχής, και επακόλουθα των θανάτων. Ξεκινά η πλήρης χαρτογράφηση των αποικισμών των πολυανθεκτικών μικροβίων στα νοσοκομεία της επικράτειας και παράλληλα καταρτίζεται το πλαίσιο για την χρήση των αντιβιοτικών σκευσμάτων τόσο στις δομές υγείας όσο και εκτός αυτών, στην κοινότητα.
Η Ελλάδα είναι μία από τις χώρες της Ευρώπης που καταγράφει ολοένα πιο μελανά στατιστικά σχετικά με το μείζον αυτό θέμα δημόσιας, και το οποίο απασχολεί σταθερά τις αρμόδιες επιστημονικές και υγειονομικές αρχές της. Το τίμημα, που πληρώνει για τη μικροβιακή αντοχή η Ελλάδα, δεν μπορεί να υπολογιστεί με ακρίβεια καθώς δεν υπάρχει η συνολική καταγραφή που να το επιτρέπει, ωστόσο εκτιμάται ότι είναι η κύρια αιτία θνησιμότητας για τουλάχιστον 2.100 άτομα ετησίως τα τελευταία χρόνια, αριθμός που τη φέρνει στην αρνητική πρώτη θέση στην ΕΕ, με δεύτερη την Ιταλία. Ενδεικτικό της διάστασης που έχει λάβει πλέον το ζήτημα της μικροβιακής αντοχής, είναι ότι το 2023 οι σχετιζόμενοι με τη λοίμωξη COVID θάνατοι στη χώρα προσέγγιζαν σε αριθμό εκείνους των λοιμώξεων από ανθεκτικά μικρόβια, ήταν 2.840 σύμφωνα με το Worldmeter. Μάλιστα, όλοι οι ειδικοί υπογραμμίζουν πως αν δεν ληφθούν δραστικά μέτρα τα επόμενα έτη, το πρόβλημα θα ενταθεί και το… μοιραίο τίμημα θα αυξάνεται.
Γνωρίζοντας τις δραματικές διαστάσεις του θέματος, η ηγεσία του υπουργείου Υγείας σε συνεργασία με τον καθ’ ύλην αρμόδιο φορέα, τον Εθνικό Οργανισμό Δημόσιας Υγείας (ΕΟΔΥ) και εκπροσώπους της επιστημονικής κοινότητας δρομολογεί ένα ολοκληρωμένο σχέδιο για την αντιμετώπισή του. Στο πλαίσιο αυτό, εντάσσεται η καταγραφή αποικισμών (μικροβίων) σε όλα τα νοσοκομεία, και αναλυτικά σε τμήματα και κλινικές τους. Είναι σημαντικό όπως επισημαίνουν οι ειδικοί να έχει χαρτογραφηθεί ο πληθυσμός των μικροβίων που προσβάλλουν τους νοσηλευόμενους, καθώς και άλλα στοιχεία, όπως η ταχύτητα, η συχνότητα, η εξέλιξη του αποικισμού, ώστε να υπάρχει η συνολική εικόνα για τις ενδονοσοκομειακές λοιμώξεις που εμφανίζονται. . Για παράδειγμα, από τα μέχρι τώρα αποσπασματικά στοιχεία που έχουν στη διάθεσή τους οι επιστήμονες από άλλες έρευνες και προγράμματα που υλοποιούνται, παρατηρούν διαφορές ανάμεσα στα τμήματα του ίδιου νοσοκομείου, αλλά και στα νοσοκομεία της Αττικής και της περιφέρειας. Ένα από τα σημαντικά στοιχεία στο οποίο επικεντρώνονται είναι πως οι ασθενείς εισάγονται στις ΜΕΘ έχοντας μολυσματικό μικροβιακό φορτίο από άλλες κλινικές ή τμήματα του νοσοκομείου.
Το πρόβλημα της μικροβιακής αντοχής που συνδέεται με την αλόγιστη και καταχρηστική κατανάλωση αντιβιοτικών θεωρείται μεγάλο και στην κοινότητα. Πολλοί ασθενείς με ήπια έως μέτρια συμπτώματα COVID-19, όπως βήχας και πυρετός, λαμβάνουν προληπτικά αντιβιοτικά για την περίπτωση που αναπτύξουν βακτηριακές λοιμώξεις. Αναφορικά με την κατανάλωση των αντιβιοτικών στη κοινότητα, η Ελλάδα κατέχει τη δεύτερη θέση μετά την Κύπρο, σύμφωνα με τα επιδημιολογικά δεδομένα του 2020.
Με αφετηρία αυτή την καταγραφή, οι επιστημονικές και υγειονομικές αρχές επικαιροποιούν το πρωτόκολλο για τη χορήγηση των αντιβιοτικών καθώς και τους όρους για τη συνταγογράφησή τους τόσο στο πλαίσιο της ηλεκτρονικής συνταγογράφησης στην κοινότητα όσο και εντός των νοσοκομείων. Επιπλέον, αναθέτουν αυξημένο ρόλο ευθύνης στις Επιτροπές Λοιμώξεων στο ΕΣΥ για την επιτήρηση των αντιβιοτικών φαρμάκων που χορηγούνται στους νοσηλευόμενους.
Πηγή: ygeiamou.gr